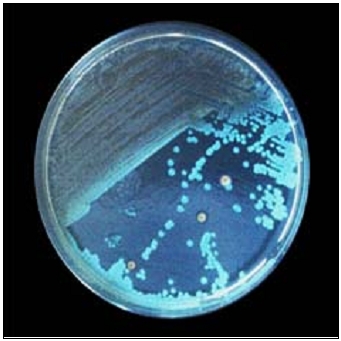

TOTAL OCEANOGRAPHIC MICROKIT®AGAR (MARINE AGAR ZOBELL)
AGAR MARINO ZOBELL (TOTAL OCEANOGRAPHIC MICROKIT® AGAR) fué diseñado para recuento total de microorganismos en productos del mar y aguas marinas.
Por ello, en su composición se emula el contenido en sales del agua de mar, al que se añaden peptonas, factores dopping de oligoelementos y agar-agar
En la imagen: Photobacterium phosphoreum, bioluminiscente, en Marine Agar. Foto en oscuridad con 1 minuto de exposición
COMPOSICIÓN
Mezcla de peptonas 6,000 g
Citrato Fe 0,100 g
Cloruro Sódico 19,450 g
Cloruro de Magnesio 8,800 g
Sulfato Sódico 3,200 g
Fosfato Disódico 0,008 g
Glucosa 2,000 g
Cloruro de Calcio 1,800 g
Cloruro de Potasio 0,550 g
Bicarbonato Sódico 0,160 g
Bromuro potásico 0,080 g
Cloruro de Estroncio 0,034 g
Silicato de Sodio 0,004 g
Fluoruro de Sodio 0,002 g
Acido Bórico 0,022 g
Nitrato amónico 0,020 g
Factores dopping c.s.
Agar-Agar 15,000 g
(Fórmula por litro)
pH: 7,6 ± 0,2
PREPARACIÓN
Disolver 56 gramos en 1 litro de agua bidestilada, calentando hasta ebullición y agitando hasta la completa homogeneización.
Es preferible añadir 5 g/L de glicerol (SDA073) para retrasar la precipitación de las sales.
Autoclavar a 121 ºC, durante 15 minutos. No sobrecalentar.
Para que el medio sea selectivo para bacterias y no crezcan hongos, añadir 0,2 g/L de Cicloheximida (SKM200 no estéril, o mejor SKM255 estéril).
PARA USO EXCLUSIVO EN LABORATORIO. MANTENGA EL BOTE BIEN CERRADO, EN LUGAR SECO, FRESCO Y OSCURO. AGITE EL BOTE ANTES DE USAR.
DESHIDRATADO CODIGO: DMT334
CONTROL DE CALIDAD DEL MEDIO
Realizado en nuestro laboratorio; es prudente repetirlo en su laboratorio siempre que varíen las condiciones (más de 3 meses sin usar, tras desinfectar laboratorio, tras conservar a alta Tª, cuando adquiere aspectos extraños aunque no haya llegado la fecha de caducidad teórica de la etiqueta,…)
DESHIDRATADO: Polvo grueso, Tostado
PREPARADO: Estéril, Ambar, Precipitado
CONTROL DE CRECIMIENTO 72 h a temperatura ambiente (21-28°C aproximadamente), ya que los microorganismos marinos son termolábiles:
Staphylococcus aureus WDCM00033, Correcto.
Listeria monocytogenes WDCM 00021, Correcto.
Aeromonas hydrophila MKTA49141**, Excelente.
Pseudomonas aeruginosa WDCM00026, Correcto, Colonias verde-amarillentas.
Escherichia coli WDCM00013, Correcto.
**Las colecciones TIPO prohíben el uso de su referencia por lo que indicamos la nuestra, directamente trazable a la colección TIPO.
PRESENTACIÓN:
MEDIO DESHIDRATADO, MEDIOS PREPARADOS A CONVENIENCIA DEL USUARIO
NOTA:
Medio optimizado para recuento total de bacterias, (y levaduras y mohos si no se añade cicloheximida) procedentes de ambiente marino. Es por ello, ideal como sustituto del PCA en agua de mar y productos de la pesca. Para anaerobios y microbiota marina especial, solicite nuevos diseños a MICROKIT.
La placa preparada de este medio debe consumirse cuanto antes, para evitar la precipitación de su alto contenido en sal marina.
SIEMBRA E INTERPRETACIÓN
Sembrar la membrana de filtración en la superficie de una placa preparada, o bien 1 ml de muestra y su serie de diluciones decimales, en placas en masa, o bien en estría en superficie. Incubar en condiciones adecuadas para saprófitos (72 h a 25°C aproximadamente) o para psicotrofos (10 días a 6°C aproximadamente). Contar todas las colonias (no filamentosas: bacterias no autótrofas y levaduras; filamentosas: hongos).
El usuario final es el único responsable de la eliminación de los microorganismos según la legislación medioambiental vigente. Autoclavar antes de desechar a la basura.
Fabricado en la UE por MICROKIT desde 1994 bajo ISO 9001, ISO 11133 y GMPs, revisado en Nov-2025
Para más información y precios actualizados contacte con microkit@microkit.es